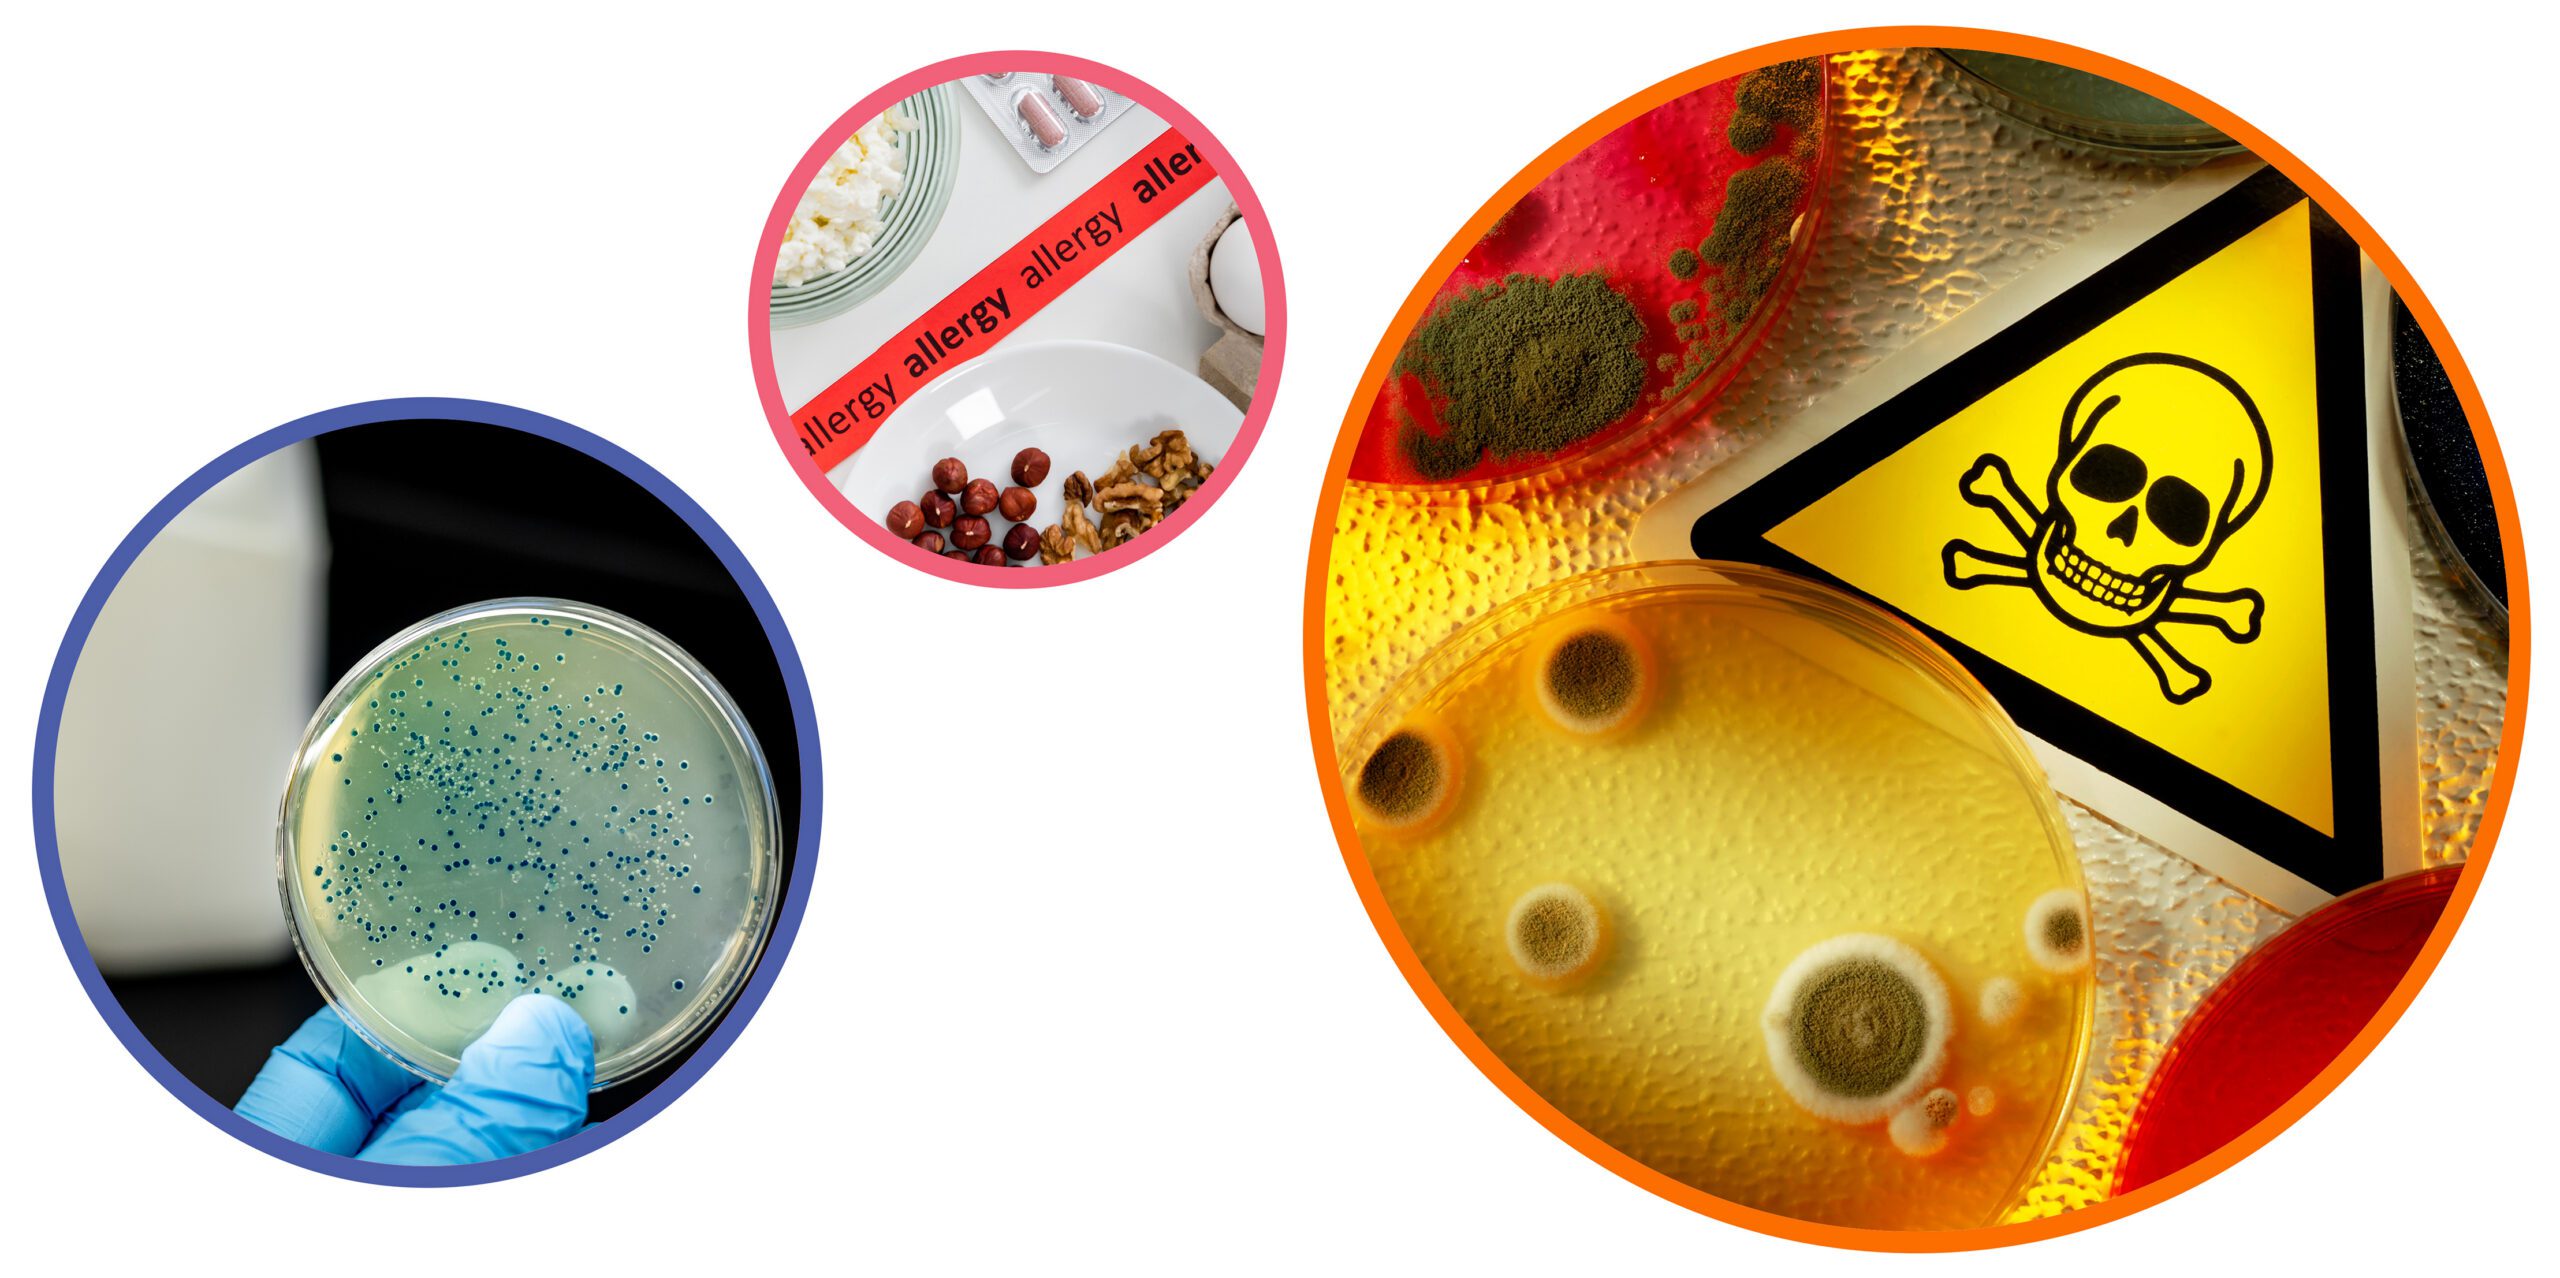
Food safety risks in manufacturing including microbial contamination, allergens, and hazardous substances

Food safety compliance gives manufacturers a reliable way to align everyday work with legal duties and customer standards. By embedding food safety and compliance into daily routines, your teams can protect consumers, reduce waste and stay audit ready.
The key is to implement a strong system that makes food safety compliance audits faster and less disruptive across your busy sites.
What is food safety compliance?
Food safety compliance is both a regulatory requirement and a practical way to run a steadier factory.
For operations, quality and technical teams the goal is to implement a system that is simple for operators, easy to evidence at audit and robust across shifts and sites.
This guide sets out what good looks like in real manufacturing environments with actions you can apply now.
Key food safety risks in manufacturing environments
Every factory faces similar hazards, though the profile shifts with product, process and environment. Focus your attention where risk is highest and prove compliance with food safety regulations through clear evidence.
Biological hazards and contamination
Biological hazards include bacteria, viruses and mould. Weak points often appear around cooking, cooling and storage where temperature control slips under pressure. And cross-contamination happens through shared equipment, utensils or staff movement between zones.
To protect against this, consider validated thermal processes, time and temperature checks, effective segregation and environmental monitoring that spots problems before product is affected and provides objective evidence that hygiene and contamination controls remain effective between product tests. Clear zoning and colour coded tools help busy teams make the right choice.
Chemical and allergen risks
Allergen cross contact remains a leading cause of recalls. Risk increases during changeovers and cleaning chemicals create hazards if dilution, contact time or rinse verification are inconsistent.
To protect against this, accurate labelling is essential. Combine validated cleaning methods, line clearance, allergen swabbing and in-line code verification. Artwork control and barcode scanning reduce mislabelling while label reconciliation checks catch issues early.
Physical contamination and foreign bodies
Foreign bodies such as metal, plastic or glass can originate from ingredients, packaging or equipment wear.
To protect against this, consider on-line barriers like magnets, sieves, metal detection or X-ray inspection. And clearly document your process to ensure any rejected material is quarantined, investigated and tracked to identify root causes.
Core elements of an effective food safety compliance approach
Stronger systems translate risk understanding into repeatable behaviours, reliable records and rapid feedback that stand up to food safety compliance audits.
Risk assessment and hazard control
HACCP principles anchor effective programmes.
Map each step, assess hazards by severity and likelihood, then define control measures. Critical control points need clear limits, frequent monitoring and immediate action when out of spec. Verification activities such as calibration, internal audit and trend reviews confirm the plan reflects reality, not just intent. Keep documentation lean and visual so operators can follow it in the shift.
Hygiene, cleaning and environmental controls
Hygiene depends on validated methods and consistent execution.
Define cleaning schedules by risk with who, what, when and how plus chemicals, concentrations and contact times. Validate new or changed procedures and revalidate after major modifications. Staff practices matter as much as equipment – manage zoning, handwashing, PPE and controlled movement between areas. Environmental monitoring for indicator organisms and pathogens provides objective evidence that controls work between product tests.
Traceability and recall readiness
End to end traceability links raw materials, intermediates and finished goods, including rework and label versions.
Lot or batch tracking at key process points shortens investigations and narrows any withdrawal. Timed mock recalls improve data capture and decision rules. If you are formalising your digital approach, this practical overview of a food safety compliance system explains how configurable forms, alerts and dashboards help teams respond faster.
Ensuring product safety across the production line
Turn standards into line-friendly routines, so risk control becomes real and measurable evidence supports food safety regulatory compliance.
Standardising processes and work instructions
Clear SOPs for high-risk tasks reduce variation between shifts and sites.
Keep instructions short, visual and mobile ready. Use photos or short clips to show methods for allergen changeovers, sanitation steps and CCP checks. Retire old versions when updates publish so there is one source of truth. Standard work enables consistent results and simplifies training.
Training and engaging operators and supervisors
Role-based training should focus on the decisions people make under time pressure.
Short refreshers tied to seasonal risks or new products keep knowledge current. Build accountability with simple sign offs, supervisor verification and prompts for escalation when checks fail. Recognition for good catches encourages reporting and strengthens the safety culture.
Monitoring, checks and verification
In line checks, inspections and sampling provide early warning.
Measure what matters and surface exceptions quickly. Use SPC or simple run charts to spot drift before it becomes a deviation. Verification activities such as pre-start hygiene checks, label reconciliation and CCP verification close the loop. Make results visible on area boards or digital dashboards so teams act on facts not assumptions.
These habits strengthen food safety and compliance in day-to-day operations.
Preparing for and managing a BRCGS audit

A BRCGS audit tests whether your documented system matches what happens on the floor. Auditors expect clear evidence, controlled documents and confident operators. The best preparation is everyday compliance with records completed at the time of activity, calibrations kept up to date and corrective actions closed with proof of effectiveness.
On the day, keep routes tidy, PPE correct and product flows obvious. Have mock recall results, environmental monitoring trends and label verification evidence ready. If a non-conformance is raised, respond with cause, immediate containment and a realistic corrective action plan that prevents recurrence.
If your team needs a walkthrough of the process and evidence points, this guide to a BRCGS audit sets expectations and helps remove surprises.
Choosing and optimising your food safety compliance system
Spreadsheets and paper struggle at scale. They slow investigations, hide trends and make version control difficult. A fit for purpose system centralises data, standardises checks and makes exceptions visible in real time. Look for flexibility to model your process, robust traceability, configurable workflows and audit trails that stand up to scrutiny.
Digital forms reduce transcription errors and prompt for photos or verification where needed. Dashboards turn raw data into insights, so leaders prioritise the right fixes. Where integrated with sensors, label control or maintenance data, these connections create a fuller picture that supports faster decisions and smoother food safety compliance audits.
How manufacturing compliance platforms support food safety

Food safety sits within broader manufacturing compliance obligations that include worker safety, environmental controls and customer requirements. A platform approach brings these elements together, reduces duplication and supports continuous improvement.
A solution like Gemba Compliance centralises records, standardises processes and provides up-to-date visibility of checks, records and exceptions across lines and sites. Configurable workflows guide operators through checks while alerts flag exceptions immediately. Automated reporting and audit logs cut preparation time and improve confidence that documentation matches reality. With integrated traceability, issue resolution is faster and narrower.
To see these capabilities in action, explore manufacturing compliance here.
Building a safer, more compliant manufacturing operation
Strong food safety compliance protects consumers and brands while enabling efficient operations. The most resilient programmes combine clear standards, engaged people and trustworthy data so issues are prevented, not just detected.





